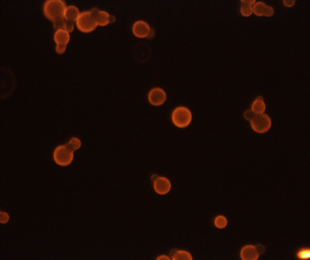

Cryptococcus immunology and vaccinology
Invasive infections caused by the encapsulated fungus Cryptococcus neoformans and its sister species, C. gattii, occur mainly in immunocompromised persons. For example, an estimated 151,000 HIV-infected persons die from cryptococcal meningitis annually, accounting for almost 20% of AIDS-related deaths. Despite the potential of reducing the global burden of disease with vaccination, there are no fungal vaccines approved for clinical use. The major goal of our research program is the development of vaccines to protect at risk persons from cryptococcosis.
We have two major Cryptococcus vaccine projects. For the first project, we are identifying protein antigens that, when packaged with adjuvants that stimulate CD4 T cell and antibody responses, act as protective vaccines. For those antigens that are protective, we are mapping the CD4 T cell epitopes and their corresponding MHC Class II alleles responsible for stimulating immunity. The second project is a collaboration with Dr. Jennifer Lodge and colleagues at Duke University to study vaccines consisting of whole Cryptococcus organisms attenuated by deletion of chitin deacetylase genes.